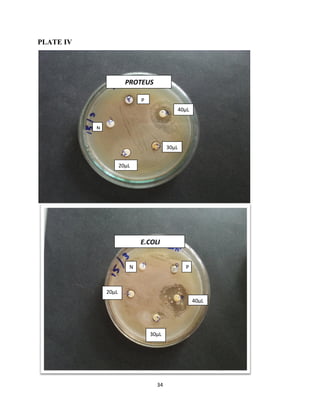
34
PLATE IV
40µL
PROTEUS
40µL
30µL
20µL
N
P
E.COLI
P
30µL
20µL
N
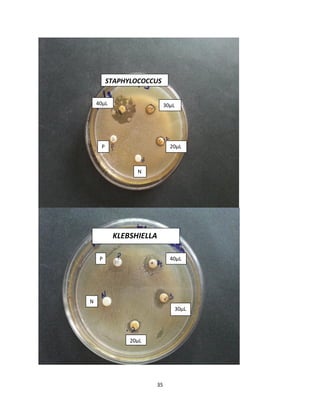
35
40µL 30µL
20µL
N
P
STAPHYLOCOCCUS
P
KLEBSHIELLA
40µL
30µL
20µL
N

Honey has been used for centuries as a treatment for infected wounds. It has antimicrobial properties due to its high osmolarity and acidity, which helps inhibit bacterial growth. Recent research has rediscovered honey's medical applications, especially for wounds that fail to heal with conventional treatments. Different types of honey from various floral sources and geographical locations have varying antimicrobial potency and effectiveness in wound healing. The objective of the study is to assess the antibacterial action of forest honey against pathogens like E. coli, Proteus, Klebsiella, and Staphylococcus aureus by screening its antibacterial properties, isolating clinical samples, and determining zone of inhibition compared to standard antibiotics.















![16
differences between the antibacterial activities of different honey types: rhododendron,
eucalyptus and orange honeys had a relatively low activity, whereas dandelion, honeydew and
rape honeys had a relatively higher activity. These results suggest that a part of the antibacterial
activity might be of plant origin. However, the antibacterial activity of sugar-adulterated honeys
was the same as that of control honeydew honeys produced in the same apiary suggesting that
the major part of the antibacterial activity of honeydew honey is of bee origin. Ten different
honeys were fractionated into four fractions using column chromatography or vacuum
distillation: acidic; basic; nonvolatile, nonpolar; and volatile. The antibacterial activity of the
different fractions tested was: acids > bases = nonpolar, nonvolatiles > volatiles. This order was
the same using either Staph. aureus or Micrococcus luteus as test strains. An exception was
manuka honey from New Zealand where almost the entire activity was found in the acidic
fraction.(Stefan Bogdanov 1997)
Development of antibiotic-resistant strains of coagulase-negative staphylococci has
complic- ated the management of infections associated with the use of invasive medical
devices,and innovative treatment and prophylactic option s are needed.Honey is increasing ly
being used to treat infected wounds, but little is known about its effectiveness against coagulase-
negative staphylococci. The aim of this study was to determine the minimum active dilution of
two standardized, representative honeys for 18 clinical isolates of coagulase-negative
staphylococci. Anagarin corporation technique was used to determine the minimum active
dilution ,with dilution steps of 1% (v/v) honey [or steps of 5% (v/v) of a sugar syrup matching
the osmotic effect of honey]. The plates were inoculated with 10 mL spots of cultures of the
isolates. Results: The honeys were inhibitory at dilutions down to 3.6–0.7% (v/v) for the pasture
honey, 3.4–0.5% (v/v) for the manuka honey and 29.9–1.9% (v/v) for the sugar syrup. Typi cal
honey sare about eight times more potent against coagulase-negative staphylococci than if
bacterial inhibition were due to their osmolarity alone. Therefore, honey applied to skin at the
insertion points of medical devices may have a role in the treatment or prevention of infections
by coagulase-negative staphylococci. (French et al., 2005)
Honey, propolis, and royal jelly, products originating in the beehive, are attractive
ingredients for healthy foods. Honey has been used since ancient times as part of traditional
medicine. Several aspects of this use indicate that it also has functions such as antibacterial,](https://image.slidesharecdn.com/finalpdf-170507110904/85/antimicrobial-activity-on-forest-honey-16-320.jpg)